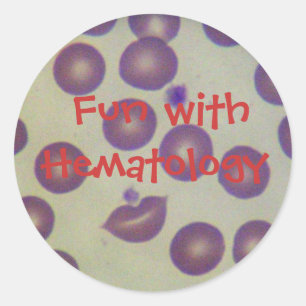
Sticker Rond Amusant avec l'hématologie

Urgence Autocollants & Stickers
1 113 résultats
Sticker Pharmacie café
Prix7,35 $CA
Sticker Carré MONOGRAMME D'OR CADUCÉ, Bleu violet
Prix27,20 $CA
Sticker Rond Ambulance classique
Prix27,20 $CA
Autocollant de Firetruck
Prix15,10 $CA
Sticker Carré Logo du service d'incendie
Prix27,20 $CA
Sticker Rond infirmière ER Caduceus
Prix27,20 $CA
Étiquette de trousse d'urgence Red Home
Prix15,10 $CA
En cas d'urgence autocollants vigilants d'animal
Prix16,00 $CA
Sticker d'alerte allergique Étiquette
Prix16,00 $CA
Sticker Rond Amusant avec l'hématologie
Prix20,60 $CA
Sticker joyeuse infirmière day bokeh
Prix7,65 $CA
Sticker Ovale joyeuse journée des infirmières BOKEH
Prix15,20 $CA
Sticker Rond Urgence suisse Roundell de Croix-Rouge
Prix16,00 $CA
Sticker Rond Faire chaque jour des terres quotidien
Prix15,80 $CA
Nuits silencieuses ! - autocollants
Prix15,50 $CA
Stickers Turquie lutte contre l'incendie
Prix17,00 $CA
Vous ne trouvez pas ce que vous recherchez ?
La Promesse Zazzle
Garantie Coup de Coeur
Vous ne l'aimez pas ? Nous le reprenons ! 30 jours pour choisir, notre "Garantie 100% coup de cœur".
Livraison Internationale Simplifiée
Expédition sans soucis, sans frais cachés. Nous couvrons les frais de douane.
Achats Sécurisés Garantis
Paiement 100% sécurisé grâce au cryptage SSL.
Avis sur la recherche
Si vous avez besoin d'assistance ou si vous avez une question, consultez notre Aide
Articles vus récemment